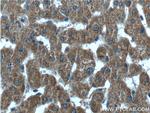
ABCA8 Antibody in Immunohistochemistry (Paraffin) (IHC (P))

Search
Proteintech
ABCA8 Polyclonal Antibody
{{$productOrderCtrl.translations['antibody.pdp.commerceCard.promotion.promotions']}}
{{$productOrderCtrl.translations['antibody.pdp.commerceCard.promotion.viewpromo']}}
{{$productOrderCtrl.translations['antibody.pdp.commerceCard.promotion.promocode']}}: {{promo.promoCode}} {{promo.promoTitle}} {{promo.promoDescription}}. {{$productOrderCtrl.translations['antibody.pdp.commerceCard.promotion.learnmore']}}
产品信息
24351-1-AP
种属反应
宿主/亚型
分类
类型
抗原
偶联物
形式
浓度
规格
纯化类型
保存液
内含物
保存条件
运输条件
产品详细信息
Immunogen sequence: SLLTMDLGR VDTFNESRFS VVYTPVTNTT QQIMNKVAST PFLAGKEVLG LPDEESIKEF TANYPEEIVR VTFTNTYSYH LKFLLGHGMP AKKEHKDHTA HCYETNEDVY CEVSVFWKEG FVALQAAI (58-184 aa encoded by bc130280 )
靶标信息
ATP-binding cassette (ABC) transporters are an evolutionarily conserved family of proteins that catalyze the transport of molecules across extracellular and intracellular membranes by harnessing the energy of ATP hydrolysis. ABCA8 (ATP-binding cassette, sub-family A (ABC1), member 8) is a 1, 581 amino acid multi-pass membrane protein that contains two ABC transporter domains and belongs to the ABC transporter family. Expressed in a variety of tissues with particularly high expression in liver, heart and skeletal muscle, ABCA8 functions as an ATP-dependent lipophilic drug transporter that exists as multiple alternatively spliced isoforms.
仅用于科研。不用于诊断过程。未经明确授权不得转售。
篇参考文献 (0)
生物信息学
蛋白别名: ABC-type organic anion transporter ABCA8; ABC-type organic anion transporter ABCA8A; ABC-type organic anion transporter ABCA8B; ATP-binding cassette sub-family A member 8; ATP-binding cassette sub-family A member 8-A; ATP-binding cassette sub-family A member 8-B; ATP-binding cassette sub-family A member 8A; ATP-binding cassette sub-family A member 8B; ATP-binding cassette, sub-family A (ABC1), member 8; unnamed protein product
基因别名: ABCA8; Abca8a; Abca8b; KIAA0822
UniProt ID: (Human) O94911, (Mouse) Q8K442, (Mouse) Q8K440
Entrez Gene ID: (Human) 10351, (Mouse) 217258, (Mouse) 27404